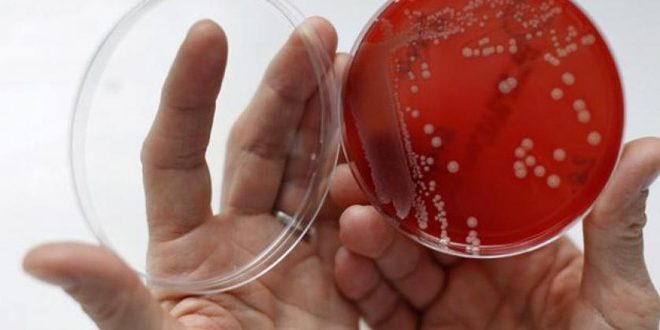

واشنطن-سانا
كشف علماء أن الاحتباس الحراري هو المسؤول عن انتشار أنواع الفطريات القاتلة في جميع أنحاء العالم كالنار في الهشيم.
ويعتقد العلماء أن ارتفاع درجات الحرارة سمح بتطور فطريات كانديدا اوريس للعيش في درجات حرارة أعلى ما يعني أنها قادرة على البقاء حية داخل أجسام البشر والتي غالبا ما تقاوم العديد من الأدوية ما يجعلها تشكل تهديدا خطيرا لصحة الإنسان.
وذكرت صحيفة ديلي ميل البريطانية أن علماء في جامعة جونز هوبكنز في بالتيمور بولاية ماريلاند الأمريكية قاموا بالتحقيق في ظهور كانديدا اوريس واقترحوا أن الاحتباس الحراري هو المسؤول عن ذلك.
وقال الدكتور أرتورو كاساديفال “الأمر غير المألوف في كانديدا اوريس” هو أنها ظهرت في 3 قارات مختلفة في الوقت نفسه ويبدو أن شيئا ما حدث وأدى إلى ظهور الفطريات ونشرها الأمراض.
وحددت الفطريات هذه في اليابان قبل عقد من الزمان ولكنها ظهرت منذ ذلك الحين في بلدان أخرى بما في ذلك الولايات المتحدة وكندا وفنزويلا وكولومبيا وجنوب إفريقيا والهند وكذلك إسبانيا والنرويج وألمانيا.
وكشفت التقارير في وقت سابق من العام أن 260 شخصا على الأقل في جميع أنحاء بريطانيا أصيبوا بالعدوى منذ عام 2012.
ومن المعروف أن درجات الحرارة القصوى تقتل الفطريات وتتفاوت الحرارة اللازمة لتدميرها عبر سلالات مختلفة وتزدهر معظم سلالات الكائنات الحية في درجات حرارة تتراوح بين 18 و22 درجة مئوية.
وتتراوح درجة حرارة جسم الإنسان بين 36 و38 درجة مئوية وهي ساخنة بدرجة كافية لقتل أو على الأقل إبطاء الإصابة بالعديد من سلالات الفطريات ولهذا السبب تتأثر الزواحف والبرمائيات بالأمراض الفطرية أكثر من الثدييات.
ولكن درجات الحرارة المرتفعة تدريجيا في العالم من حولنا يمكن أن توفر للكائنات وقتا للتكيف مع ارتفاع درجات الحرارة.
وفي الدراسة تمكنت فطريات كانديدا اوريس من البقاء على قيد الحياة عند درجات حرارة أعلى مقارنة بالفطريات الأخرى المماثلة ما يشير إلى تطورها.
وأضاف الدكتور كاساديفال “ما تقترحه الدراسة هو أن هذه هي بداية تكيف الفطريات مع ارتفاع درجات الحرارة وسنواجه المزيد من المشكلات مع مرور
الوقت وسيؤدي الاحتباس الحراري إلى اختيار الأنساب الفطرية الأكثر تحملا حراريا بحيث يمكنها اختراق منطقة التقييد الحراري للثدييات”.
كما أوضحت الدراسة أن ظهور كانديدا اوريس يمكن أن يكون علامة تحذير على أن المزيد من الفطريات التي نادرا ما تصيب البشر ستتكيف مع الأمراض.
وحذر الدكتور كاساديفال من أن السلطات الصحية في جميع أنحاء العالم بحاجة إلى تعزيز قدرتها على تتبع الالتهابات الفطرية بالطريقة نفسها المستخدمة لمراقبة البكتيريا والفيروسات.
تابعوا آخر الأخبار عبر تطبيق تيلغرام على الهواتف الذكية عبر الرابط:
https://telegram.me/SyrianArabNewsAgency
تابعوا صفحتنا على موقع (VK) للتواصل الاجتماعي على الرابط:
S A N A الوكالة العربية السورية للأنباء